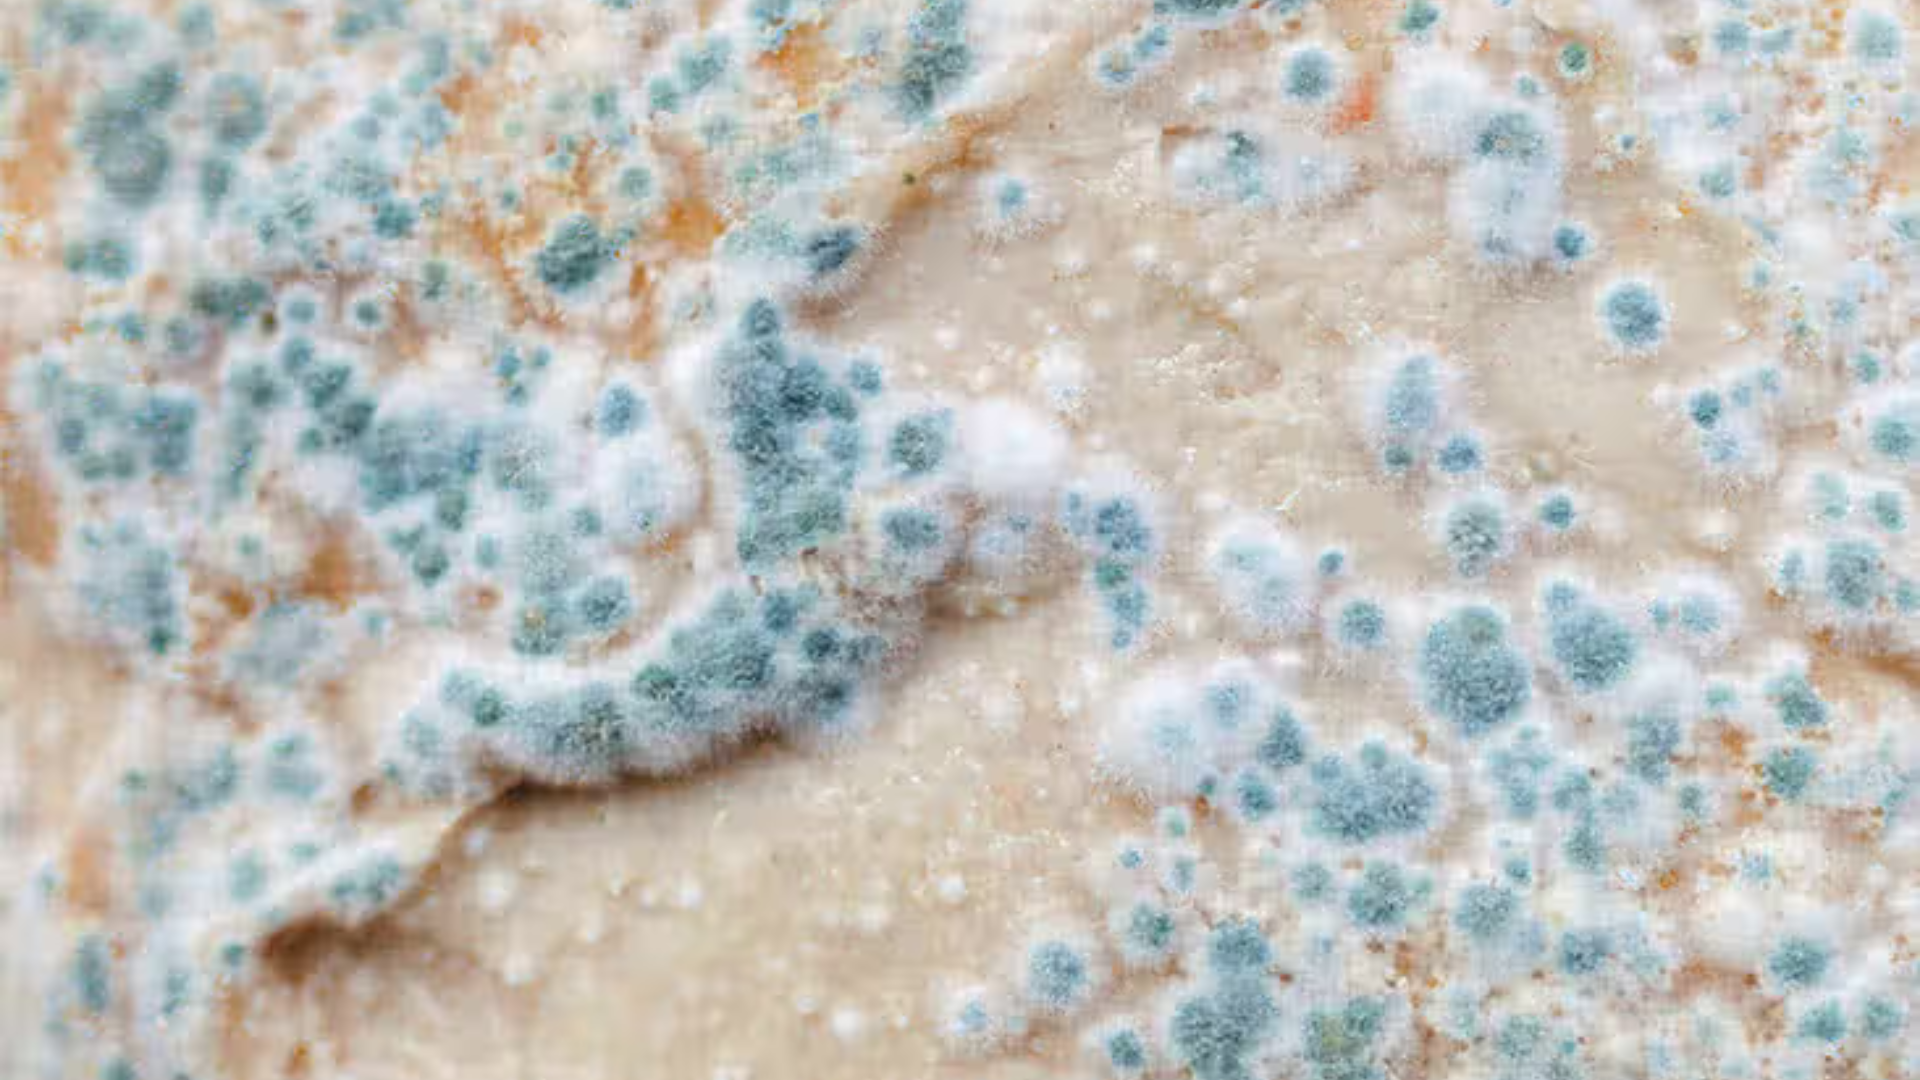
Cladosporium thường có màu xanh ô-liu, nâu sẫm hoặc đen, bề mặt mịn như nhung

Nấm mốc thường phát triển ở nơi ẩm thấp và kém thông thoáng mà mắt thường khó nhận biết hết. Khi tìm hiểu nhận diện các loại nấm mốc thường gặp và ảnh hưởng của chúng tới sức khỏe, mình sẽ hiểu rõ hơn mức độ tác động của từng loại. Từ đó, việc bảo vệ sức khỏe cá nhân và gia đình trở nên chủ động và hiệu quả hơn.
Aspergillus
Aspergillus là một trong các loại nấm mốc thường gặp nhất trong môi trường sống hàng ngày, đặc biệt ở không khí, bụi nhà và các khu vực ẩm thấp như nhà tắm, máy lạnh, kho chứa đồ. Loại nấm này thường có màu xanh lục, vàng, nâu hoặc đen, phát triển nhanh chóng ở nơi kín gió, ít thông thoáng.
Đặc điểm và độc tố
Một số loài Aspergillus còn sản sinh độc tố aflatoxin mạnh, có thể liên quan đến tổn thương gan nếu tiếp xúc lâu dài qua thực phẩm bị mốc hoặc hít phải bào tử.

Ảnh hưởng đến sức khỏe
Về sức khỏe, Aspergillus dễ gây các triệu chứng sau:
- Kích ứng đường hô hấp: Kích ứng mũi họng, ho kéo dài, khó thở.
- Dị ứng nặng hơn: Dị ứng hô hấp nặng hơn ở người bị hen suyễn, COPD hoặc đang hóa trị ung thư.
- Nguy cơ aspergillosis: Nếu bạn hay gặp triệu chứng hô hấp mà nhà có dấu hiệu ẩm mốc, hãy kiểm tra sớm để tránh tình trạng aspergillosis, nhóm bệnh nhiễm nấm phổi do Aspergillus gây ra.
Cách tốt nhất để phòng tránh loại nấm này là giữ độ ẩm nhà dưới 60%, lau chùi thường xuyên và dùng máy hút ẩm nếu cần.
Penicillium
Penicillium là loại nấm mốc thường gặp trên bánh mì cũ, trái cây hỏng, phô mai hoặc thực phẩm để lâu ngày. Chúng thường có màu xanh lam hoặc xanh lục nhạt, lan nhanh thành lớp mịn trên bề mặt.
Dù một số loài Penicillium được dùng sản xuất kháng sinh penicillin và phô mai ngon, nhưng nhiều loài khác lại gây hại khi hít bào tử hoặc ăn phải thực phẩm nhiễm mốc.
Triệu chứng khi tiếp xúc
Chúng có thể dẫn đến các biểu hiện sau:
- Hắt hơi và nghẹt mũi.
- Viêm xoang, đau đầu.
- Phản ứng dị ứng mạnh.
Lưu ý với trẻ nhỏ
Đặc biệt với gia đình có trẻ nhỏ, hệ miễn dịch còn yếu, nên loại bỏ ngay thực phẩm có dấu hiệu mốc Penicillium để tránh tích tụ độc tố ảnh hưởng đến sức khỏe lâu dài. Khi thấy thực phẩm có lớp mốc xanh, tốt nhất là vứt bỏ toàn bộ chứ không nên cắt bỏ phần mốc vì bào tử đã lan sâu bên trong.
Cladosporium
Cladosporium là loại nấm mốc thường gặp cả ngoài trời lẫn trong nhà, hay bám trên tường ẩm, rèm cửa, thảm trải sàn, cửa sổ và hệ thống thông gió. Nấm này thường có màu xanh ô-liu, nâu sẫm hoặc đen, bề mặt mịn như nhung. Cladosporium phát tán bào tử mạnh trong không khí, đặc biệt mùa mưa hoặc độ ẩm cao. Đây là một trong những nguyên nhân phổ biến gây dị ứng.
Biểu hiện dị ứng
Các triệu chứng thường gặp bao gồm:
- Ngứa mũi và mắt.
- Chảy nước mũi.
- Ho khan.
- Làm nặng thêm hen suyễn.
Biện pháp kiểm soát
Nếu nhà bạn kín gió, ít ánh sáng tự nhiên thì nguy cơ tiếp xúc Cladosporium cao hơn, cần thường xuyên lau chùi và thông thoáng để giảm bào tử trong không khí. Sử dụng quạt hút hoặc mở cửa sổ hàng ngày cũng giúp giảm đáng kể sự phát triển của loại nấm này.
Stachybotrys
Stachybotrys còn gọi là nấm mốc đen, hay xuất hiện trên vật liệu xây dựng ẩm lâu ngày như thạch cao, trần nhà, giấy dán tường bị thấm nước. Loại nấm này phát triển chậm nhưng lại sinh ra mycotoxin mạnh, gây lo ngại lớn khi tiếp xúc kéo dài trong không gian kín.
Triệu chứng khi tiếp xúc
Triệu chứng thường gặp khi tiếp xúc Stachybotrys bao gồm:
- Mệt mỏi kéo dài.
- Đau đầu.
- Kích ứng mắt mũi họng.
- Thậm chí buồn nôn.
Khuyến cáo xử lý
Các tổ chức y tế khuyến cáo không tự xử lý nấm mốc đen diện rộng mà cần kiểm soát độ ẩm, thông gió tốt và nhờ chuyên gia nếu nghi ngờ nhiễm nặng để tránh rủi ro sức khỏe nghiêm trọng hơn. Nếu nhà bạn từng bị ngập nước hoặc rò rỉ mái hiên, hãy kiểm tra kỹ các khu vực tối ẩm để phát hiện sớm Stachybotrys.
Alternaria
Alternaria là loại nấm mốc thường gặp ngoài trời, phát triển trên cây cối, đất ẩm, thực vật mục nát và dễ xâm nhập nhà qua cửa sổ hoặc không khí. Đặc trưng là màu nâu đậm hoặc đen, thường thành mảng lớn với kết cấu nhung.

Đây là tác nhân dị ứng phổ biến, đặc biệt gây các vấn đề sau:
- Viêm mũi dị ứng theo mùa.
- Hen phế quản.
- Ho kéo dài và khò khè.
Thời điểm nguy cơ cao
Alternaria tăng mạnh vào mùa mưa khi bào tử bay nhiều trong không khí, nên người có tiền sử dị ứng cần chú ý giữ nhà cửa khô ráo và dùng máy lọc không khí nếu cần.
Cách hạn chế xâm nhập
Tránh để lá cây mục hoặc đất ẩm gần cửa sổ cũng là cách đơn giản để hạn chế Alternaria xâm nhập vào không gian sống.
Mucor
Mucor là loại nấm mốc thường gặp phát triển nhanh trên thực phẩm hỏng, đất ẩm và bề mặt hữu cơ phân hủy. Chúng thường có màu trắng xám, dạng bông xốp dễ nhận biết bằng mắt thường.

Nguy cơ mucormycosis
Trong y tế, Mucor đáng chú ý vì có thể gây mucormycosis, một loại nhiễm trùng hiếm nhưng nghiêm trọng, chủ yếu ở người tiểu đường không kiểm soát hoặc suy giảm miễn dịch.
Phòng ngừa trong sinh hoạt
Dù ít gặp trong sinh hoạt thường ngày, việc giữ nhà khô sạch, thông thoáng vẫn giúp hạn chế nguy cơ tiếp xúc bào tử Mucor hiệu quả. Khi thấy thực phẩm có lớp mốc trắng xốp, hãy vứt bỏ ngay và vệ sinh tủ lạnh, khu vực bếp núc để ngăn nấm lan rộng.
Tóm lại, để bảo vệ sức khỏe khỏi các loại nấm mốc thường gặp, bạn nên thực hiện các biện pháp sau:
- Kiểm soát độ ẩm: Giữ độ ẩm trong nhà dưới 60%, sử dụng máy hút ẩm nếu cần.
- Thông gió tốt: Mở cửa sổ thường xuyên, sử dụng quạt hút ở nhà tắm và bếp.
- Vệ sinh định kỳ: Lau chùi điều hòa, tủ lạnh, các góc tường ẩm thường xuyên.
- Xử lý rò rỉ nước: Sửa chữa ngay các vị trí thấm nước, rò rỉ ống nước.
- Loại bỏ thực phẩm mốc: Vứt bỏ toàn bộ thực phẩm có dấu hiệu mốc, không cắt bỏ phần mốc.
Các loại nấm mốc thường gặp có thể tồn tại âm thầm trong môi trường sống và ảnh hưởng đến sức khỏe nếu không được nhận diện và kiểm soát kịp thời. Việc hiểu rõ đặc điểm từng loại giúp bạn chủ động phòng tránh, đặc biệt với gia đình có trẻ nhỏ, người cao tuổi hoặc người có bệnh hô hấp.
Trên đây là những thông tin về nhận diện các loại nấm mốc thường gặp và ảnh hưởng của chúng tới sức khoẻ mà bạn có thể tham khảo. Khi nghi ngờ môi trường sống có nấm mốc ảnh hưởng đến sức khỏe, nên tham khảo ý kiến của nhân viên y tế hoặc đơn vị chuyên môn để được tư vấn phù hợp.
:format(webp)/470051785_8767135473405056_691967411107495592_n_6b2bbff755.png)
:format(webp)/467434554_545745841560409_1066418224364723785_n_560a494f9c.png)
/Phen_chua_1_eb67d86e1d.jpg)
/uong_nuoc_que_co_tot_khong_loi_ich_rui_ro_and_cach_dung_an_toan_8e39e30db6.jpg)
/uong_nuoc_ngai_cuu_tuoi_co_tac_dung_gi_loi_ich_and_luu_y_an_toan_211b672f82.jpg)
/thuc_pham_dong_lanh_an_thuong_xuyen_co_tot_cho_suc_khoe_khong_e3f24ceae2.jpg)
/qua_la_han_co_tac_dung_gi_ai_nen_dung_va_dung_sao_cho_dung_754dbb413d.jpg)